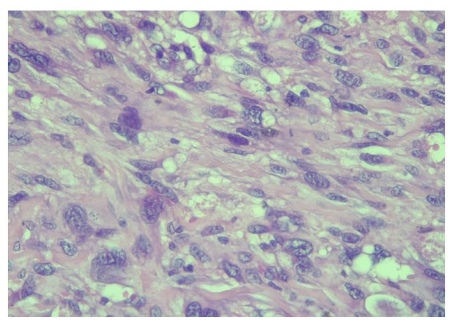

Review Article
Volume-1 Issue-1, 2023
Undifferentiated Male Urethral Sarcoma Revealed by a Urethral Trauma
-
Received Date: April 10, 2023
-
Accepted Date: May 10, 2023
-
Published Date: May 12, 2023
Journal Information
![]() |
| Figure 1: Budding tumor of the perineal urethra |
![]() |
| Figure 2: (HE x 400): ovoid or fusiform sarcomatous cells with distinct cytonuclear atypia |
Introduction
Key words
Urethral; Malignant Tumours; Pleomorphic Sarcoma; Liposarcoma
Smooth tissue sarcomas represent less than 1% of adult malignant tumours and 10 to 20% of teenagers and young adult tumours [1-4]. Genito-urinary forms are extremely rare and represent 1% to 2% of malignant tumours of the urogenital sphere [4]. There are several subtypes of smooth tissue sarcomas, and the most aggressive histological types are the liposarcoma, the leiomyosarcoma and the undifferentiated pleomorphic sarcoma [5]. Such histopathological diversity constitutes one of the anatomopathological diagnosis difficulties, essentially based on morphological, immunohistochemical and genetical analyzes [5]. The clinical signs are non-specific and most often reflect a banal stricture of urethra, which delays diagnosis. We present the first case of unclassifiable undifferentiated male urethra sarcoma, unusual by its localization and circumstances of discovery.
Observation
M. ABJ., 21 years old presented to our emergency department with an acute urine retention. His history included perineal trauma with urethral bleeding by falling astride on a bicycle handlebar that occurred five weeks before his admission. In his background, there was no recurrent bulbar urethral strictures, no alcohol, no smoking, and no history of familial cancer. A suprapubic catheter was placed in emergency. On pelvic examination, we noticed a penoscrotal and perineal induration that were absent before the trauma. Urethrocystoscopy demonstrated an obliterated urethra. We performed end to end urethroplasty. The follow-up was marked by the persistence of bleeding and the appearance of a perineal tumour ulcerous budding (Figure 1).
The pelvic MRI revealed a heterogeneous mass of bulbo membranous urethra and no lymph nodes metastatic. Thoraco-abdominal scan showed no distal metastatic disease. A bulbo-urethrectomy with removal bulbo-cavernous muscles and perineal skin was performed. Histological examination of urethrectomy specimen after inclusion, sectioning and haematein-eosin staining showed a connective tumour proliferation with a fasciculated and storiform architecture. Tumour cells are pleomorphic with cytonuclear atypia, and a mitotic index evaluated at 3 mitoses per 10 fields at 400x magnification. Tumour cells were positive for vimentin on immunohistochemistry. Tumour cells were negative for S100, HMB45, Smooth muscle actin, CKAE1/AE3, MDM2, CD117, DOG1, CD34 and EMA. Fluorescent in situ hybridization did not have the synovialosarcoma-specific t (X; 18) translocation. Pathological examination concluded to an undifferentiated sarcoma of the urethra unclassifiable grade II according to the FNCLCC. (Figure 2).
An early recurrence of the tumour was observed. The patient dead after few months.
Discussion
Genitourinary soft tissue sarcomas are extremely rare. they represent 1 to 2% of all genitourinary malignancies [4]. The largest cohort of genitourinary sarcomas reported in the literature included 188 cases in China [4]. Genitourinary sarcomas can affect men at any age; for urethral sarcomas, the average age could be around 56 years with extremes ranging from 24 to 73 years according to the literature [6,7]. Our patient was younger and had an age below the cases reported in the literature [6,8]. The etiopathogenesis of male urethral sarcoma is still unknown and many etiological factors have been incriminated. The main factors are intensive radiotherapy and genetic diseases such as neurofibromatosis type 1 or Von Recklinghausen disease, Li Fraumeni syndrom and bilateral hereditary retinoblastoma [5]. The discovery of a soft tissue sarcoma in a young person requires systematic oncogenetic consultation to look for predisposing genes. Undifferentiated unclassifiable round cell sarcomas harbour CIC-DUX4 or BCOR-CCNB3 fusion genes [5].
The diagnosis of soft tissue sarcomas is known to be difficult despite advances in the organisation of management and advances in histopathological analysis techniques [3]. Anatomopathological diagnosis is based on histological study, immunohistochemistry and molecular biology from biopsy fragments or surgical excision parts.
The curative treatment of sarcoma is essentially surgical and based on wide surgical excision to achieve local control of the tumour. Poor initial surgical management can compromise prognosis [3,4]. Mutilating surgery is the standard for locally advanced forms. Partial penectomy with a 2 cm safety margin can be performed for locally advanced tumours of the penile urethra infiltrating the corpora cavernosa. Cysto-prostato-urethrectomy can be performed via the abdominal-perineal approach for non-metastatic tumours of the bulbo-membranous urethra. The excision can be enlarged, extended to the whole penis (radical penectomy), or even to the scrotum (emasculation) and further to the pubic arch (pubectomy) [2]. It may be combined with radio-chemotherapy. Radiotherapy is used in locally advanced forms of the bulbo-membranous urethra. Brachytherapy uses iridium 192 at a dose of 60 to 65 Gy delivered in 5 days and external radiotherapy, daily doses of 18 to 20 Gy. As an adjuvant treatment, it can improve local control in the case of a positive surgical margin [9]. Chemosensitivity in soft tissue sarcoma is considered intermediate [9], and is part of a multimodal management approach [9]. Isolated chemotherapy is the only option for extensive metastases [1,2]. The most commonly used drugs are doxorubicin, ifosfamide, vincristine, cyclophosphamide, and dacarbazine, but doxorubicin alone remains the standard [2].
Because of their extreme rarity, the survival of urethral sarcomas will be compared with that of other genitourinary sarcomas. Overall survival in patients with soft tissue sarcoma at any stage is poor at around 50-60%, and 5-year recurrence-free survival is rare [2,4]. The low 5-year survival rate is explained by the large size of the tumour (median 8 cm) and the existence of metastases (25.5%) at the time of diagnosis and by the high histological grade (80.9%) [2-4].
Local tumour recurrence after surgical removal is common and accounts for 26% of cases with an average delay of 25 months [2]. Predictive factors for tumour recurrence were tumour size, metastasis and positive surgical margin [2,4]. High- -grade malignant sarcomas are mostly undifferentiated and are characterised by a high prognostic potential, both locally and metastatically [1, 3-5].
Conclusion
The undifferentiated sarcoma of male urethra is an extremely rare and aggressive tumour.
The rarity of that disease is one of the limitation factors for clinical and pathological research explaining the diagnosis and therapeutic difficulties.
Persistent urethrorrhagia or peri-urethra mass should suggest urethral sarcoma. The diagnosis is based primarily on pathological examination of tumour tissue samples. The treatment of localized forms is mainly based on wide surgical resection with resection margins of at least 2 cm.
The current research advances in molecular biology opens perspectives in pathological diagnosis by identification of new molecular subtypes and on therapeutic aspect by the development of new treatments said “targeted”.
References
- Poon E, Quek R (2018) Soft tissue sarcoma in Asia. Chin Clin Oncol. aout 7: 46.
- Stojadinovic A, Leung DHY, Allen P, Lewis JJ, Jaques DP et al. (2002) Primary Adult Soft Tissue Sarcoma: Time-Dependent Influence of Prognostic Variables. JCO 20: 4344-52.
- Cho SY, Moon KC, Cheong MS, Kwak C, Kim HH et al. (2011) Localized Resectable Genitourinary Sarcoma in Adult Korean Patients: Experiences at a Single Center. Yonsei Med J 52: 761.
- Wang X, Tu X, Tan P, Zhan W, Nie P et al. (2017) Adult genitourinary sarcoma: Clinical characteristics and survival in a series of patients treated at a high-volume institution. Int J Urol. Juin 24: 425-31.
- Doyle LA (2014) Sarcoma classification: An update based on the 2013 World Health Organization Classification of Tumors of Soft Tissue and Bone: WHO Update of Sarcoma Classification. Cancer. 15 juin 120: 1763-74.
- Ahallal Y, Tazi MF, Khallouk A, Tazi E, Benlemlih A et al. (2009) Primary leiomyosarcoma of the male urethra: a case report. Cases Journal 2: 207.
- De Angelis R, Sant M, Coleman MP, Francisci S, Baili P et al. (2014) Cancer survival in Europe 1999–2007 by country and age: results of EUROCARE-5-a population-based study. The Lancet Oncology 15: 23-34.
- Nogueira MA, Santos GCL dos, Lopes RI, Campos OHA, Dall’Oglio MF et al. (2015) Male urethral sarcoma: a case report and literature review. Einstein (São Paulo) 14: 64-6.
- Eastley N, Green PN, Ashford RU (2016) Soft tissue sarcoma. BMJ i436.
Article Information
Review Article
Received Date: April 10, 2023
Accepted Date: May 10, 2023
Published Date: May 12, 2023
Undifferentiated Male Urethral Sarcoma Revealed by a Urethral Trauma
Volume 1 | Issue 1
Citation
GOWE Edy Edmond (2023) Undifferentiated Male Urethral Sarcoma Revealed by a Urethral Trauma. J Urol Renal Disord. 1: 1-4
Copyright
©2023 GOWE Edy Edmond. This is an open-access article distributed under the terms of the Creative Commons Attribution License, which permits unrestricted use, distribution, and reproduction in any medium, provided the original author and source are credited.
doi: judu.2023.1.101